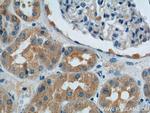
SNX1 Antibody in Immunohistochemistry (Paraffin) (IHC (P))

Search
Proteintech
SNX1 Polyclonal Antibody
{{$productOrderCtrl.translations['antibody.pdp.commerceCard.promotion.promotions']}}
{{$productOrderCtrl.translations['antibody.pdp.commerceCard.promotion.viewpromo']}}
{{$productOrderCtrl.translations['antibody.pdp.commerceCard.promotion.promocode']}}: {{promo.promoCode}} {{promo.promoTitle}} {{promo.promoDescription}}. {{$productOrderCtrl.translations['antibody.pdp.commerceCard.promotion.learnmore']}}
产品信息
10304-1-AP
种属反应
已发表种属
宿主/亚型
分类
类型
抗原
偶联物
形式
浓度
规格
纯化类型
保存液
内含物
保存条件
运输条件
产品详细信息
Immunogen sequence: QDQEPQDLF ADATVELSLD STQNNQKKVL AKTLISLPPQ EATNSSKPQP TYEELEEEEQ EDQFDLTVGI TDPEKIGDGM NAYVAYKVTT QTSLPLFRSK QFAVKRRFSD FLGLYEKLSE KHSQNGFIVP PPPEKSLIGM TKVKVGKEDS SSAEFLEKRR AALERYLQRI VNHPTMLQDP DVREFLEKEE LPRAVGTQTL SGAGLLKM (81-287 aa encoded by BC000357 )
靶标信息
This gene encodes a member of the sorting nexin family. Members of this family contain a phox (PX) domain, which is a phosphoinositide binding domain, and are involved in intracellular trafficking. This endosomal protein regulates the cell-surface expression of epidermal growth factor receptor. This protein also has a role in sorting protease-activated receptor-1 from early endosomes to lysosomes. This protein may form oligomeric complexes with family members. This gene results in three transcript variants encoding distinct isoforms.
仅用于科研。不用于诊断过程。未经明确授权不得转售。
生物信息学
蛋白别名: MGC8664; SNX1 splice variant; SNX1A; sorting nexin 1A; Sorting nexin-1; unnamed protein product
基因别名: HsT17379; SNX1; VPS5
UniProt ID: (Human) Q13596, (Mouse) Q9WV80, (Rat) Q99N27
Entrez Gene ID: (Human) 6642, (Mouse) 56440, (Rat) 84471